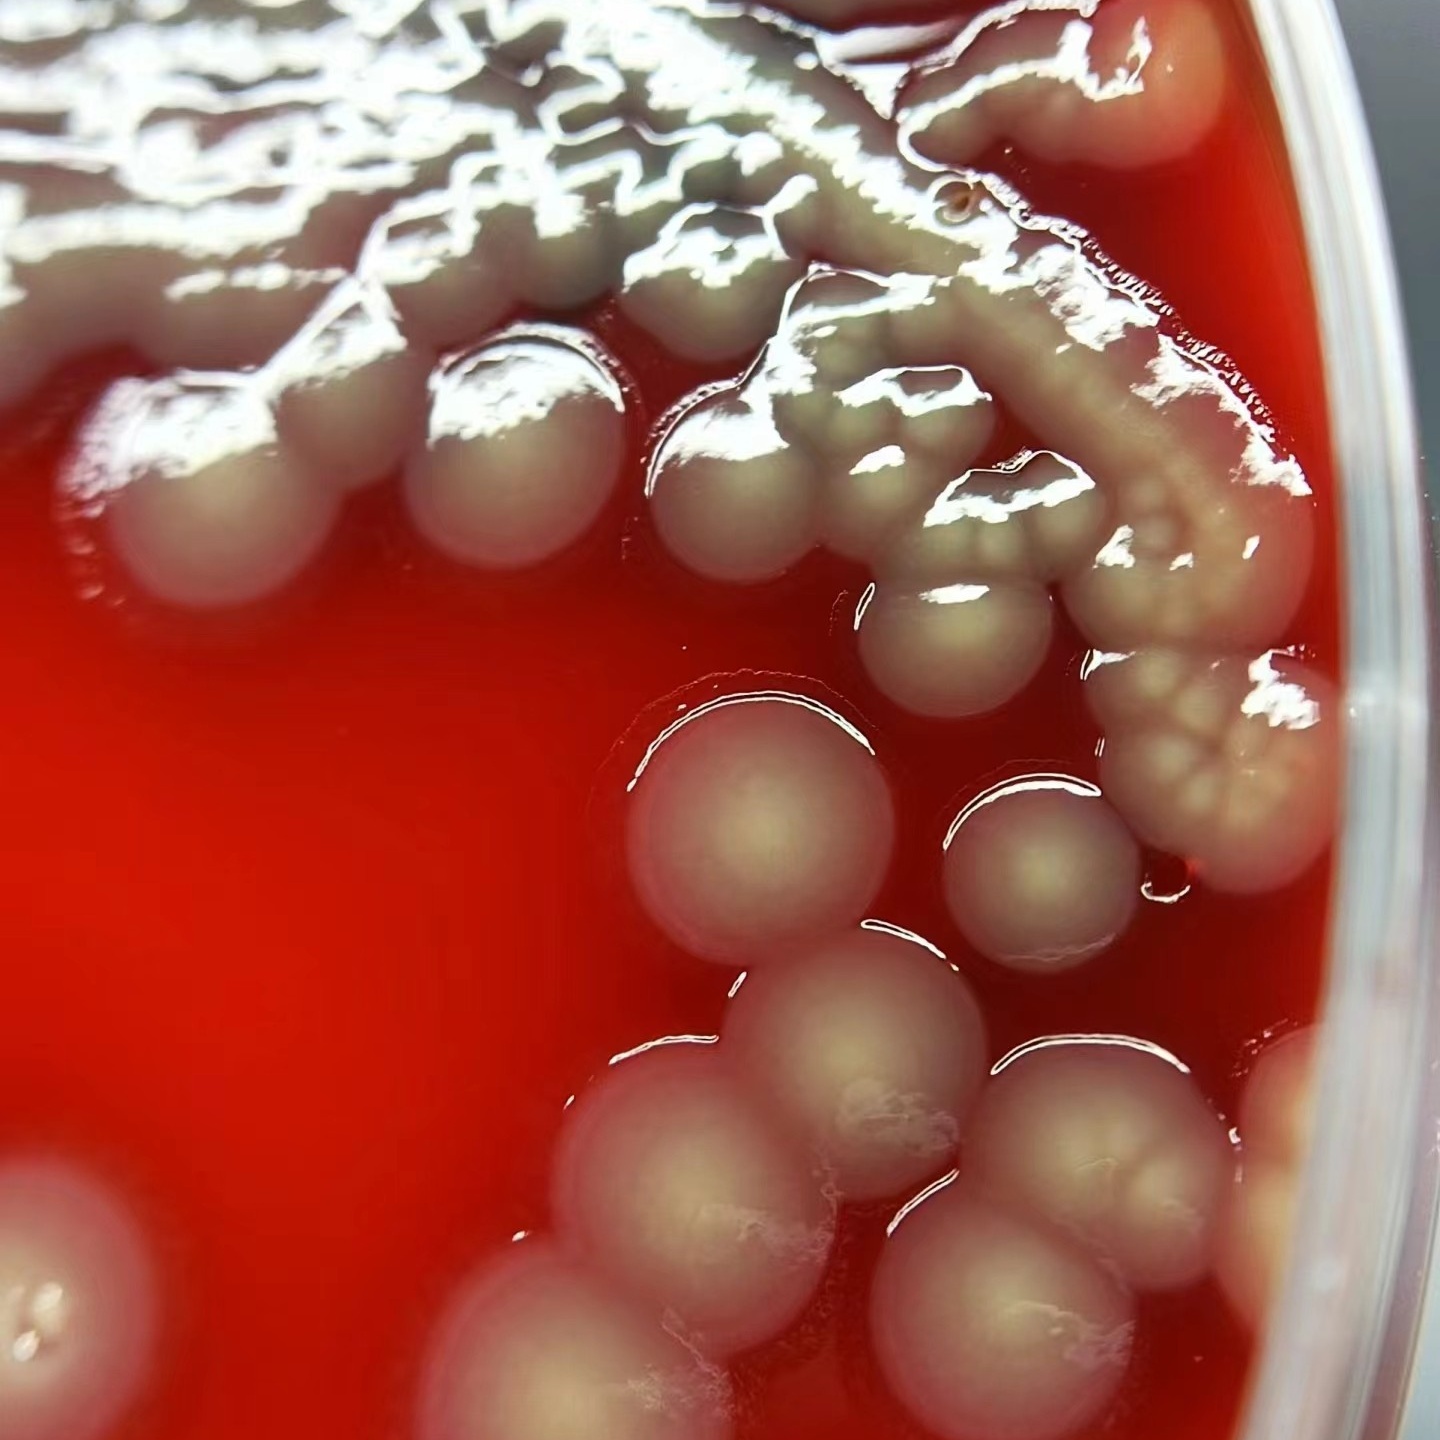
微信圖片_20240927100651.jpg

科普 | 銅綠假單胞菌:如何破除耐藥性細(xì)菌的防御壁壘?
隨著經(jīng)濟(jì)的發(fā)展和生活水平的提高,人們對日化產(chǎn)品的需求不斷提高。日化產(chǎn)品生產(chǎn)工藝較為簡單,一般沒有像食品和藥品生產(chǎn)時(shí)必須經(jīng)過滅菌或除菌工藝,而且日化產(chǎn)品是一種多次重復(fù)使用的商品,從而容易微生物污染而腐敗變質(zhì)。變質(zhì)的日化產(chǎn)品會產(chǎn)生異味、分層、變色和霉斑等現(xiàn)象,同時(shí)微生物生長繁殖過程中產(chǎn)生的毒素,會引起使用者皮膚過敏等炎癥,危害人體健康,失去其商品價(jià)值。
日化產(chǎn)品腐敗霉變的微生物以革蘭陰性細(xì)菌為主,其中的主要類群為伯克霍爾德氏菌屬、多細(xì)菌源菌屬、克雷伯氏菌屬、假單胞菌屬、腸桿菌屬。其中銅綠假單胞菌屬于假單胞菌屬,與金黃色葡萄球菌和耐熱大腸菌群都是國家標(biāo)準(zhǔn)監(jiān)控的病菌。本文將詳細(xì)介紹銅綠假單胞菌,它在日化產(chǎn)品的腐敗霉變過程中扮演著不容忽視的角色。
銅綠假單胞菌簡介
銅綠假單胞菌(Pseudomonas aeruginosa)是一種革蘭氏陰性桿菌,廣泛存在于自然環(huán)境中的細(xì)菌,可以在土壤、水體、植物表面等處生存。它具有非常強(qiáng)的適應(yīng)性,能適應(yīng)各種惡劣環(huán)境條件。它是一種重要的環(huán)境微生物,因其對多種抗生素和消毒劑具有高度耐藥性而聞名。銅綠假單胞菌在醫(yī)療、工業(yè)及日化產(chǎn)品中均可能引起問題,尤其是在產(chǎn)品的微生物安全性方面。
銅綠假單胞菌具有以下特點(diǎn):
耐藥性機(jī)理

銅綠假單胞菌的耐藥性主要出現(xiàn)在β-內(nèi)酰胺類抗生素、氟喹諾酮類、氨基糖苷類以及生物膜保護(hù)下的化學(xué)消毒劑(如過氧化氫和季銨鹽類)上。這種耐藥性使得控制和消滅銅綠假單胞菌變得復(fù)雜,需采取綜合措施應(yīng)對。

銅綠假單胞菌的耐藥機(jī)理對產(chǎn)品安全和質(zhì)量控制提出了嚴(yán)峻挑戰(zhàn),主要有以下六點(diǎn):
日化產(chǎn)品的配方:銅綠假單胞菌的外膜結(jié)構(gòu)限制了許多常用殺菌劑的滲透,導(dǎo)致消毒效果不理想。日化產(chǎn)品在配方設(shè)計(jì)時(shí)需考慮選擇能夠穿透外膜的成分。
02 抗生素酶的產(chǎn)生
防腐劑的選擇:銅綠假單胞菌能夠產(chǎn)生β-內(nèi)酰胺酶等酶,水解特定防腐劑。企業(yè)需選擇多種防腐劑組合,以降低被酶水解的風(fēng)險(xiǎn),確保產(chǎn)品的長期穩(wěn)定性。
03 靶點(diǎn)改變的適應(yīng)性
產(chǎn)品開發(fā)的挑戰(zhàn):細(xì)菌通過改變靶點(diǎn)來抵抗抗生素,這對日化行業(yè)的抗菌產(chǎn)品開發(fā)提出挑戰(zhàn)。企業(yè)需要不斷創(chuàng)新,選用新型的抗菌成分,以應(yīng)對細(xì)菌的適應(yīng)性變化。
04 增強(qiáng)的排出泵
抗菌效果降低:銅綠假單胞菌的排出泵可以主動(dòng)排出抗菌成分,降低其有效性。配方需要考慮增強(qiáng)抗菌成分的結(jié)合力,來克服這一機(jī)制。
05 生物膜形成的挑戰(zhàn)
產(chǎn)品使用環(huán)境:在潮濕或多菌環(huán)境中,銅綠假單胞菌易形成生物膜,增加其對抗菌劑的抵抗力。日化產(chǎn)品在使用場景的設(shè)計(jì)上需要考慮生物膜的影響,可能需要添加專門的生物膜清除成分。
耐藥性傳播:能夠通過水平基因轉(zhuǎn)移快速獲得耐藥基因,意味著一旦出現(xiàn)耐藥性污染,可能迅速擴(kuò)散,影響多個(gè)產(chǎn)品線。
應(yīng)對建議

· 加強(qiáng)原材料控制
選擇信譽(yù)良好的供應(yīng)商,確保原材料的質(zhì)量符合標(biāo)準(zhǔn)。在采購前進(jìn)行微生物檢測,確保原料的安全性。
· 優(yōu)化生產(chǎn)流程
建立嚴(yán)格的生產(chǎn)流程和操作規(guī)程,確保每個(gè)環(huán)節(jié)都經(jīng)過消毒處理。定期對生產(chǎn)設(shè)備進(jìn)行清潔和滅菌,尤其是在產(chǎn)品換線時(shí)。
· 實(shí)施環(huán)境監(jiān)測
定期監(jiān)測生產(chǎn)環(huán)境中的微生物水平,尤其是在高風(fēng)險(xiǎn)區(qū)域(如灌裝區(qū)、儲存區(qū)等)。通過空氣和表面采樣,及時(shí)發(fā)現(xiàn)潛在的污染源。
· 使用有效的消毒劑
采用針對銅綠假單胞菌的高效消毒劑,如含氯、過氧化氫等產(chǎn)品,確保能夠有效殺滅細(xì)菌。消毒劑的選擇應(yīng)考慮其在產(chǎn)品中的相容性。
· 建立應(yīng)急處理機(jī)制
制定應(yīng)急預(yù)案,一旦發(fā)現(xiàn)產(chǎn)品中存在銅綠假單胞菌污染,能夠迅速采取隔離、召回和消毒等措施,減少對消費(fèi)者的影響。
銅綠假單胞菌的耐藥機(jī)理在日化行業(yè)中帶來了多重挑戰(zhàn)。企業(yè)需要在產(chǎn)品配方、生產(chǎn)流程和市場監(jiān)測等方面采取綜合措施,確保產(chǎn)品的安全性與有效性。通過創(chuàng)新研發(fā)、強(qiáng)化監(jiān)測、和適時(shí)調(diào)整策略,可以有效應(yīng)對銅綠假單胞菌的威脅,維護(hù)消費(fèi)者的健康和企業(yè)的信譽(yù)。
若對銅綠假單胞菌有任何困擾,
歡迎聯(lián)系迪美業(yè)務(wù)人員為您解答!


